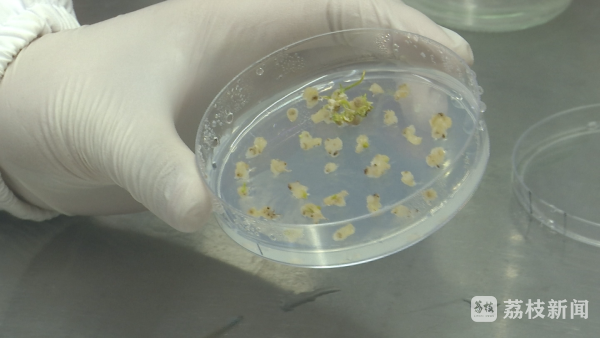

赤霉病,被称为小麦的"癌症"。二十多年来,万象城awcsport官网应用植物基因组团队师生为了攻克这个世界级难题,砥砺前行、默默耕耘。今年春节,团队成员仍然坚守在实验室,攻关小麦种质创新和品种选育。

万象城awcsport官网应用植物基因组团队教授贾海燕,为了照料小麦实验材料,今年寒假没有回老家与亲人团聚,留守实验室,每天和研究生们一起浇水、施肥、除草,记录每株小麦的生长情况。

人工气候室里这一百多盆小麦材料,大多携带已经克隆的小麦抗赤霉病Fhb1基因,汇集了我国五大小麦主产区的主栽品种,因为生态区不同,需要低温处理的时间不同,发育阶段也不同,因此需要对每一棵悉心照顾。

“光照也好,温度也好,我可以通过人工智能去设置。但是水,我是没法人工智能去浇的。”贾海燕告诉记者,“就是材料越大,它蒸腾得越快,需要水分就越多;材料小,需要水分就少。我每一个盆的材料长得高高低低都不一样,就要根据材料实际需要,去给它确定用水的量,才能够保证材料在合适的水分供应下正常生长。”

研究生侯朵朵今年也没回家。人工气候室里,有一盆小麦材料是她历经三个多月杂交培育出来的,从抗病基因移植到种苗培养,侯朵朵不想错过每一个环节,“它关系到国家的粮食生产和粮食安全。我父母也是农民,他们深知粮食对国家发展的重要性,他们也知道从事这份工作的辛苦和漫长。”

近年来,由于气候变暖、秸秆还田、免耕技术的推广和水肥条件的改善,小麦赤霉病发生日趋严重。

在江苏,赤霉病现已成为小麦生产的第一大病害,几乎两到三年就出现一次中度到大的病害流行。南农大应用植物基因组团队负责人马正强教授说,“因为它难以治愈,没有好的办法去对付病害,所以我们称它为像人的癌症一样,称之为小麦中的癌症。”

1998年从美国康乃尔大学遗传育种学博士毕业回国后,马正强进入万象城awcsport官网工作,他组建团队,将赤霉病抗性研究,作为主攻方向。经过20多年的科研跋涉,马正强团队克隆了小麦中目前已知的最重要的抗赤霉病基因Fhb1。该基因具有最强的抗扩展效应,还可降低籽粒中真菌毒素的积累。

“这个基因来源是比较有意思的,它是来自于我们江苏一个地方品种。”马正强介绍,“我们把这个基因克隆出来以后,通过分子育种,成功育成了高抗赤霉病的这样一个材料,现在我们很多育种家、育种单位,就能利用我们这个材料作为亲本,来育成新的抗赤霉病的品种。”

“口感上面会有区别吗?”针对记者提出的疑问,马正强表示,“我们做了研究,比如像这个材料,它的品质水平跟它原来的授体亲本,基本上是没有什么差异的,就是不影响它的品质,也不会影响它的口感。”
“小麦赤霉病抗性的提高,是一个世界性的难题。”贾海燕教授告诉记者,为了解决这个难题,团队通过多年的研究,挖掘出了控制赤霉病抗性关键的基因,“为了把这个基因用到生产当中去,那么我们就采用在温室加代快速繁殖的方法,一年三代。那么如果大田去种的话,那么从找到这个基因,到把它应用到育种当中去,就需要8到10年的时间。而我们就通过这种在人工气候室里面,给它365天不停地去生长,快速生长,这样我就可以在2到3年内,就可以把我们好的基因,导入到生产中的品种当中去,用于生产推广。”

团队采用分子育种策略,将Fhb1在内的多个抗赤霉病基因,导入到来自江苏、山东、河南、四川等小麦主产区的中感或高感赤霉病小麦品种中,这些基因的应用,能使小麦抗赤霉病扩展的能力提高76%以上,在玉米等其他作物中,也可能提高其抗镰刀菌病害的能力。

2025年,马正强希望有更多的品系能够进入品种区域试验、品种比较试验或者是品种审定,“我们目前在研究另外几个很重要的基因,其中一个是抗赤霉病侵染的基因,还有影响小麦籽粒发育的基因,还有一些影响小麦品质的基因,我们希望这些工作,能够在今年有更大的一些进展。”

【荔枝新闻】新春走基层: “麦田守望者"攻坚小麦赤霉病
原文链接:
阅读次数:583
【 转载本网文章请注明出处 】